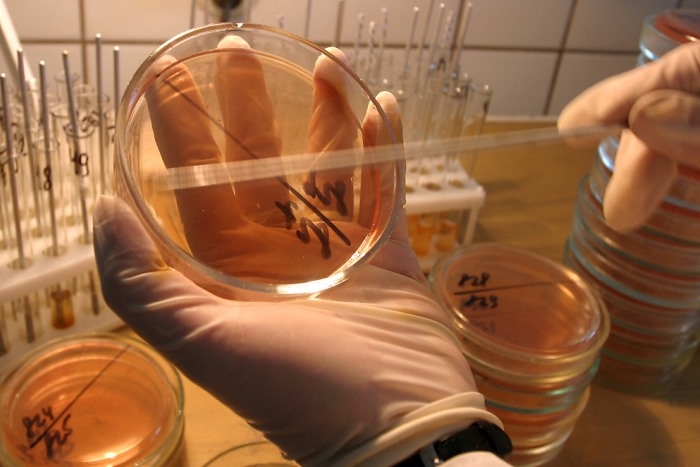

Учёные открыли супербактерию, вызывающую бесплодие
Иллюстративное фото
Микроб под названием Mycoplasma genitalium (M. genitalium) практически нечувствителен к большинству антибиотиков.
Инфекция передается половым путем и способна вызвать воспаления уретры, матки, фаллопиевых труб, и, как следствие, бесплодие.
Диагностика осложняется тем, что микроорганизм похож на другие бактерии, а неправильное лечение приводит к еще большим осложнениям.
Заметили ошибку? Пожалуйста, выделите её и нажмите Ctrl+Enter








